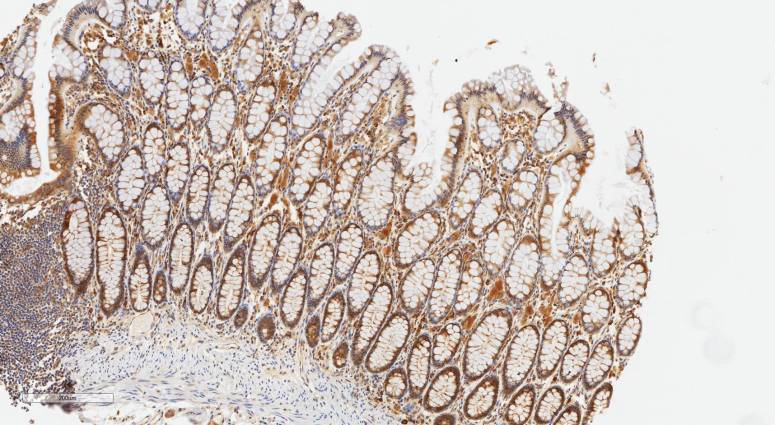
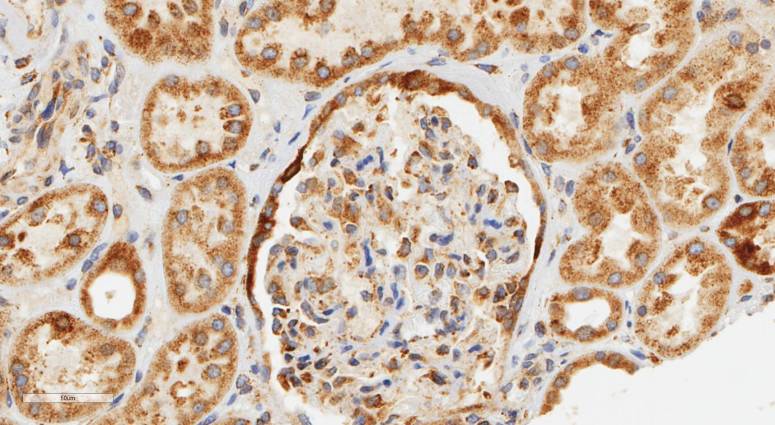

Do you like pretty immunohistochemistry pictures? Well, good news! Click the buttons below or read on for a lay -friendly overview of what we’ve done in our recent paper and why it matters.

What’s it about?
Laminins are awesome. 40+ years of study have revealed that they play essential roles in maintaining the integrity of every tissue in the body, they also act as signalling hubs that can change many aspects of cell behaviour including regulating proliferation, and differentiation and they also provide substrates for cell migration such as during tissue development and wound repair. If that isn’t enough, laminins and the basement membrane structure that they form part of, are essential to the formation of barriers in the body such as those that stop tumours from invading but also that regulate the selective passage of immune cells from the blood supply into tissues. Part of this diversity in function is down to there being 12 different laminin genes which are expressed in different tissues at different times and in response to different stimuli.
So far so good, but where do LaNts come in? Well the laminin N terminus proteins, or LaNts, are the newest members of the laminin superfamily. So far they’ve only been studied in the skin and the surface of the eye but we have always thought that they are likely to be expressed (and likely functional) in other locations too. Importantly, knowing where a protein is is the first step toward understanding what it does, and what we have learned from the laminins is that context matters!
In this study, Dr Lee (Leeburt) Troughton set about finding out where LaNt a31 (the prototypical member of the LaNt family) is located in a wide-range of adult human tissues. To do so we made new antibodies against the protein and used them to probe panels of human sections using a procedure known as immunohistochemistry. This approach uses an enzymatic reaction to generate a brown stain wherever the antibodies have bound. The blue stain in the pictures is used to to recognise the nucleus in the tissue sections which is really useful for identifying structures. In addition to LaNt a31 he also probed for laminin alpha3 which is genetically related to LaNt a31 but has been widely and so provides a useful reference point.
What did we learn?
Genuinely loads of stuff.
First the expected. We anticipated that LaNt a31 would be found in the bottom layer of epithelial sheets (skin, the lining of the digestive tract (see above), the larynx) and that’s what we observed. We also thought that blood vessels would express the protein and again, the data supported that hypothesis.
However, once we got to the internal organs like kidney, liver and spleen we didn’t really know what to expect. That’s the really fun element of this sort of study. Everything is totally new and whatever we see tells us something that not only we don’t know but also that no one knows. Turns out LaNt a31 is in distinct structures in each of these tissues, most strikinglyit is enriched in different types of the kidney tubules and around the edges of pancreatic acini.
But the surprises didn’t end there. When we arrived at the cerebellum, cerebral cortex and spinal cord we found LaNt a31 in Purkinje neurons. What is it doing there? We don’t know yet! But now we know where to look.
There’s actually lots more in the paper. Check it out to find LaNt in your favourite tissue. It’s probably there!
What next?
Knowing where to find a protein in healthy individuals is just the beginning.
Now we know where to look, we know what to investigate next. By “we” I mean the collective scientific community (collaborators welcome). Obvious questions are what does LaNt do in these tissues? Is it required for normal function, does it change during development, in old age, in different disease conditions? My team are beginning to ask some of these questions, so stay tuned for some answers soon.

2 Comments